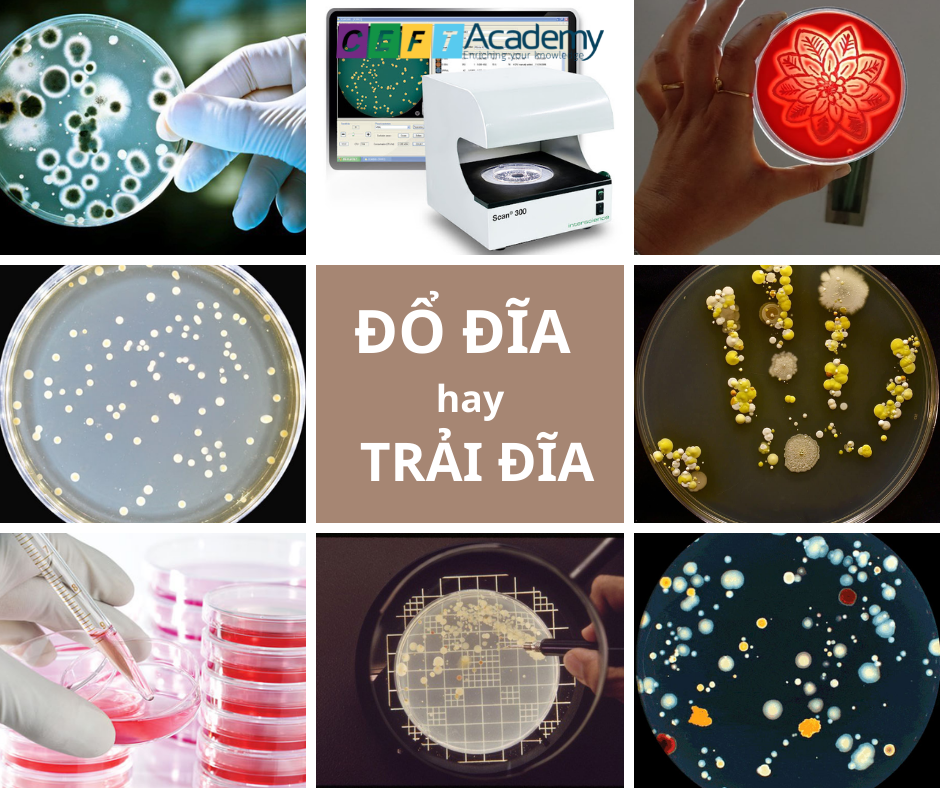

-
-
-
Tổng tiền thanh toán:
-
// thay = width tương ứng
// thay = height tương ứng
03 DECEMBER 2021
Đổ Đĩa hay Trải Đĩa?
Mình có cơ hội tiếp xúc nhiều với các bạn sinh viên học ngành thực phẩm, vi sinh, các bạn đang làm trong mảng phân tích vi sinh ở các phòng thí nghiệm nội bộ, một năm kinh nghiệm có, nhiều năm kinh nghiệm có. Tuy nhiên, mình thấy một tỉ lệ không nhỏ các bạn làm theo bản năng, mà không biết vì sao phải làm thế này, vì sao phải làm thế kia.
Câu hỏi mà mình thường gặp nhất là: Nên dùng phương pháp đổ đĩa (Pour) hay trải đĩa (Spread) ?
Trong bài viết này, mình sẽ đi lại kiến thức sơ khởi nhất về vi sinh: Đổ đĩa và trải đĩa, khi nào có thể sử dụng được?
1. Điểm khác biệt: Điểm khác biệt cơ bản nhất của 2 phương pháp:
- Đổ đĩa: thì mình chuẩn bị môi trường ở dạng nóng chảy (40-50 độ C). Sau khi đã hút (cấy) mẫu vào đĩa petri trống thì mình mới đổ môi trường vào.
- Trải đĩa: Mình chuẩn bị đĩa petri đã có môi trường bên trong đó (dạng rắn), sau đó hút mẫu vào trải đĩa.
2. Thế mạnh của từng phương án:
- Đổ đĩa: Rất nhanh: bạn cứ hình dung, hút mẫu vào đĩa petri mất 5s, đổ môi trường mất 5s, sau đó lắc 5s, để tự đông đặc nên có thể nói là siêu nhanh.
- Ngược lại: thế mạnh chính của phương pháp trải đĩa: Vì tất cả các vi sinh vật đều năm trên bề mặt thạch, nên nếu hình thái giống nhau thì được xem như là 1 con (tất nhiên không đúng 100%), vì vậy trải đĩa rất thích hợp để kiểm tra độ thuần của chủng, kiểm tra sự đa dạng vi sinh vật trong mẫu, cũng như trong nghiên cứu,… Tất nhiên, còn nhiều thế mạnh khác như: áp dụng cho các môi trường đục,…
3. Vậy điểm yếu của từng phương án:
- Đổ đĩa: Cái này mà gặp các môi trường đục thì bó tay (BPA, MYP,…), hoặc những mẫu mà vi sinh vật nền nhiều, cần phân tách để test sinh hóa mà đổ đĩa thì “bó tay”.
- Trải đĩa: Nếu bạn nào đã học qua môn nuôi cấy vi sinh thì cũng đã trả qua quá trình ngồi trải đĩa, trải nửa tiếng đồng hồ chưa khô. Giả sử tay nghề thành thạo rồi, thì cũng mất khoảng 2p để trải khô lượng địa này. Chưa nói đến các bước chuẩn bị đĩa petri trước đó cũng vô cùng nhiêu khê. Và thời gian phân tích lâu thì rủi ro về việc nhiễm chéo càng tăng lên.
- Và còn rất nhiều …. Nữa nhé.
4. Vậy thì mình cần chọn phương án nào:
- Thông thường nếu các bạn phân tích theo ISO, TCVN, AOAC,… thì thực ra họ thường chỉ định phương án luôn rồi.
Nếu trong nghiên cứu thì mình có thể lựa chọn phương án phù hợp dựa vào các thông tin trên.
- Tuy nhiên một số tiêu chuẩn như TPC, Mốc,… không ép buộc, thì phương án được khuyến nghị là dùng phương pháp đổ đĩa nhé: sẽ tiết kiệm được khá nhiều thời gian, giảm rủi ro tạp nhiễm (trừ khi có mục đích khác nhé).
5. Trên là góc nhìn của bản thân mình, vấn đề rất đơn giản, nhưng mình thấy nhiều bạn còn lăn tăng nên mình chia sẻ, hy vọng nhận được phản hồi từ các bạn!
#CEFTworks #CEFTacademy #petri #Phantichvisinh